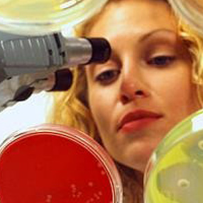
Profile picture

Rasha Elsayim
Doctorate
-
Doctorate Student / Research AssistantCollege of Science, King Saud UniversityRiyadh, Saudi Arabia
